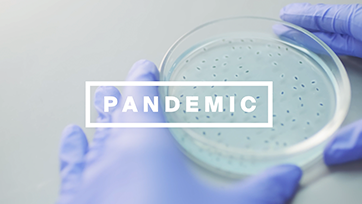

In CAIS You Missed It
Mercer & The Power of the Independent Advisor
Video
• 1 min
Cara Williams, Family Offices, Financial Intermediaries & Multinational Clients-Wealth at Mercer, joins Matt Brown to discuss the power of independent financial advisors in the US. FOR INSTITUTIONAL INVESTOR USE ONLY. The information contained in this video is provided for educational and illustrative purposes only and is not intended to be relied upon as a forecast, research or investment advice, and is not a recommendation, offer or solicitation to buy or sell any securities or to adopt any investment strategy. The opinions expressed are subject to change without notice. Information contained herein may have been obtained from a range of third party sources. While the information is believed to be reliable, Mercer has not sought to verify it independently. As such, Mercer makes no representations or warranties as to the accuracy of the information presented and takes no responsibility or liability (including for indirect, consequential, or incidental damages) for any error, omission or inaccuracy in the data supplied by any third party. Reliance upon information in this video is at the sole risk and discretion of the reader. The material was prepared without regard to specific objectives, financial situation or needs of any investor. Important Notices. References to Mercer shall be construed to include Mercer LLC and/or its associated companies. © 2020 Mercer LLC. All rights reserved. This contains confidential and proprietary information of Mercer and is intended for the exclusive use of the parties to whom it was provided by Mercer. Its content may not be modified, sold or otherwise provided, in whole or in part, to any other person or entity without Mercer's prior written permission. Mercer does not provide tax or legal advice. You should contact your tax advisor, accountant and/or attorney before making any decisions with tax or legal implications. This does not constitute an offer to purchase or sell any securities. The findings, ratings and/or opinions expressed herein are the intellectual property of Mercer and are subject to change without notice. They are not intended to convey any guarantees as to the future performance of the investment products, asset classes or capital markets discussed. For Mercer’s conflict of interest disclosures, contact your Mercer representative or see http://www.mercer.com/conflictsofinterest. This does not contain investment advice relating to your particular circumstances. No investment decision should be made based on this information without first obtaining appropriate professional advice and considering your circumstances. Mercer provides recommendations based on the particular client's circumstances, investment objectives and needs. As such, investment results will vary and actual results may differ materially. Information contained herein may have been obtained from a range of third party sources. While the information is believed to be reliable, Mercer has not sought to verify it independently. As such, Mercer makes no representations or warranties as to the accuracy of the information presented and takes no responsibility or liability (including for indirect, consequential, or incidental damages) for any error, omission or inaccuracy in the data supplied by any third party. Investment management and advisory services for U.S. clients are provided by Mercer Investments LLC (Mercer Investments). Mercer Investments LLC is registered to do business as “Mercer Investment Advisers LLC” in the following states: Arizona, California, Florida, Illinois, Kentucky, New Jersey, North Carolina, Oklahoma, Pennsylvania, Texas, and West Virginia; as “Mercer Investments LLC (Delaware)” in Georgia; as “Mercer Investments LLC of Delaware” in Louisiana; and “Mercer Investments LLC, a limited liability company of Delaware” in Oregon. Mercer Investments LLC is a federally registered investment adviser under the Investment Advisers Act of 1940, as amended. Registration as an investment adviser does not imply a certain level of skill or training. The oral and written communications of an adviser provide you with information about which you determine to hire or retain an adviser. Mercer Investments’ Form ADV Part 2A & 2B can be obtained by written request directed to: Compliance Department, Mercer Investments, 99 High Street, Boston, MA 02110. Certain regulated services in Europe are provided by Mercer Global Investments Europe Limited and Mercer Limited. Mercer Global Investments Europe Limited and Mercer Limited are regulated by the Central Bank of Ireland under the European Union (Markets in Financial Instruments) Regulation 2017, as an investment firm. Registered officer: Charlotte House, Charlemont Street, Dublin 2, Ireland. Registered in Ireland No. 416688. Directors: Sylvia Cronin, Michael Dempsey, Tom Geraghty, Abhishek Krishan, Deborah Mintern, Bruce Rigby (British) and Vincent Sheridan. Mercer Limited is authorized and regulated by the Financial Conduct Authority. Registered in England and Wales No. 984275. Registered Office: 1 Tower Place West, Tower Place, London EC3R 5BU. Investment management services for Canadian investors are provided by Mercer Global Investments Canada Limited. Investment consulting services for Canadian investors are provided by Mercer (Canada) Limited.